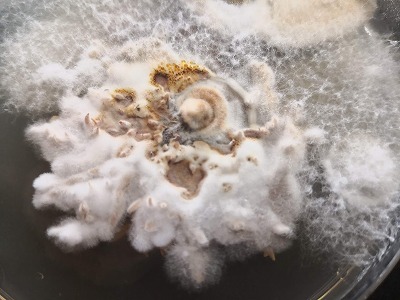

|
|
6月21日 |
| |
2020年春、個人邸のサクラの伐採勧告を行った。
これまでの経緯を説明します。
2015年、1本のサクラの診断依頼があった。それが次の写真になります。当年の開花もイマイチであったらしい。 |
|
 |
 |
|
2015年5月撮影 |
2015年8月撮影 |
|
それぞれに3本のサクラが写っていますが、診断対象は中央のサクラです。 なんとなく葉が少なく、しかも色が薄いことがお分かり頂けると思います。
決定的な原因は掴めず『根詰まりか何かだろう…』と予測診断を行った。
そして翌年、土壌調査を兼ねた・・・というか根の蘇りを期待した土壌改良を行った。 (※結果的にこれが正解であったと思われる。) |
|
.jpg) |
.jpg) |
|
2016年1月 土壌改良作業の実施。 それなりの太さの根が枯れている事が解る。 |
|
根元周辺の土壌を改良材を混和して埋め戻した。 |
|
|
 |
 |
|
2016年4月 |
平2016年7月 |
|
ここで良く診て頂きたい。わざわざ撮影したのではなく、隣にあるので写り込んでしまっただけであるが、両隣のサクラは元気なのである。
平成28年7月の写真など、両隣(特に右側)の葉色はよく樹勢も良いことが解る。
|
|
 |
 |
|
2017年4月 |
2018年4月 |
|
写真のみでは少々解り難いが、中央のサクラの開花状況は少しづつではあるが良くなっている。
そしてその両隣のサクラの開花も問題ない。というかしっかり咲いている。
|
|
 |
 |
|
2018年4月26日 (土壌改良から2年後) |
2019年4月 開花も良くなってきた |
|
土壌改良の甲斐があったためか、枝葉が増えて葉色が濃くなってきた。 多少の枯れ枝はあるものの樹勢は回復傾向にあるように見える。
そして、事件は突然やってきた。 この土壌改良を施したサクラの両隣のサクラが、開花後に一気に枯れ始めたのである。 |
|
 |
.jpg) |
|
2020年4月の開花状況 |
2020年6月 |
|
中央のサクラは例年通りであるが、両隣は開花が悪いように見える。
|
開花後、一旦は葉が展開したが、その後、すべて萎凋し枯死した。
|
|
.jpg) |
.jpg) |
|
サクラ(左)葉の状態。水ストレスにより萎凋したように見える。 |
サクラ(右) 同様である。 |
|
この原因は何か? 一旦は開花し葉も展開し始めた・・・が、一気に枯死に向かった。つまり、これは葉が展開し一気に蒸散量が増加したが
その必要な水分を供給できなかった、つまり根に原因があると判断した。 後日、根の調査を行った。
|
|
.jpg) |
.jpg) |
|
2020年6月 枯れたサクラの根の調査 |
採取した根の状況 |
|
採取した根の樹皮下には、白い菌糸の膜が拡がっていた。一見は Armillaria属菌(ナラタケ)の病害が疑われた。
菌糸の束が見つからなかったことから、『ならたけもどき病』がもっとも疑われた。
(しかし、不思議なことにキノコ臭はしなかった・・・相変わらず鼻は利かない・・・。)
採取した根を持ち帰り、同定するために組織培養を試みた。
|
|
 |
|
|
培地上に形成された根状菌糸束 |
|
この結果をもって『ならたけもどき病』による枯死と断定した。
さて、ここでこれまでの経緯をたどってみよう。 2015年に診断したサクラはおそらく『ならたけもどき病』であったのだろう。
それが両隣のサクラに感染させたと考えるほうが自然であろうか。この病気は厄介で土中で他の樹木に感染させる能力を保持しているのである。
つまり最初に中央の個体に施術するときに両隣も含めて施術すべきであったのだろう。
最初にこの病気であると断定できなかったことが敗因であろうか。
まぁ、・・・・ もし、その当時にナラタケと気がついたら何も手が出せなかったかもしれないが・・・・
中央のサクラはなぜ枯れなかったのか??
実は、使用した土壌改良剤に効果があったとしか思えない。 そのうたい文句には、
『微生物活性化作用により、植物に有効な微生物群が増加し、有機物の分解が促進されて、植物に養分として取り入れやすくなります。 また放線菌などは、糸状菌などの病原菌に対する抗菌活性もあることから、病害抑制にも効果を発揮します。』
とある。やはり菌の拮抗作用であると推測する。
この資材を私は多用している。 科学的な証明は無いが、この資材が関与したお蔭でサクラが枯れなかったという事例を他でも聞いている。
エピローグ:
6月25日、両隣のサクラは伐採された。そして出来る限りの伐根も行った。
.jpg) |
.jpg) |
| 枝を払った後、重機で幹を引くと簡単に抜けた。 根の支持力が無い証拠。 |
さらに、周辺のサクラへ担子菌類に効果があるという殺菌剤を土壌注入した。
これは気休めにしかならないかもしれないが、少なくとも土壌伝搬の妨げにはなるであろうか。
|
|
|
|
 |